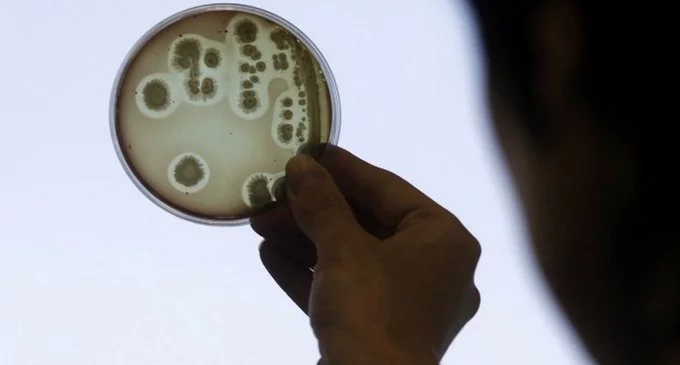
Científicos dan con la clave para vencer a las 'superbacterias' con antibióticos resistentes

TECNOLOGÍA

¿Adiós a las gafas?: Crean una pantalla que corrige la visión
Investigadores del MIT y de la Universidad de California han desarrollado una nueva pantalla que corrige automáticamente los defectos de visión sin necesidad de usar ningún tipo de lentes o gafas.

La teletransportación cuántica será una realidad
El físico ruso Serguei Filippov y su colega eslovaco Mario Ziman han desarrollado un método de teletransporte de fotones -partículas diminutas capaces de almacenar información- a distancia.

Lentes de contacto inteligentes, la nueva apuesta de Google
El gigante tecnológico anunció que su filial dedicada a la oftalmología firmó un acuerdo de licencia con el grupo farmacéutico suizo Novartis

Descubren por qué la memoria guarda recuerdos desagradables
Un grupo de científicos españoles ha identificado una proteína que influye en el mecanismo de la memoria para guardar más o menos cantidad de recuerdos aversivos o malas experiencias vitales y hacerlo con mayor o menor profundidad.

Un microchip devuelve la vista a una invidente en una operación pionera en España
Aurora Castilla es la primera española que ha recuperado la vista parcialmente gracias a un microchip de visión artificial.
Científicos dan con la clave para vencer a las 'superbacterias' con antibióticos resistentes
Un grupo de científicos de una universidad británica ha logrado un gran avance en el desarrollo de un fármaco contra las 'superbacterias' resistentes a antibióticos que amenazan la salud global.

Facebook Messenger ahora permite compartir mensajes en video
Los usuarios del servicio de mensajería móvil de la red social podrán enviar pequeños videos de 15 segundos de duración, igual que en Instagram.

Astrónomos al Congreso de EE.UU.: Se podría hallar vida extraterrestre dentro de 20 años
Es muy probable que encontremos vida alienígena en nuestra galaxia en los próximos 20 años, aseguraron expertos astrónomos ante el Congreso de EE.UU. "Sería extraño que estuviéramos solos", cree uno de ellos.

"Intercambié mi cuerpo con otra persona"
¿Qué pasaría si uno pudiera probar cómo es vivir en el cuerpo de otra persona? Algunos lo hicieron y experimentaron profundos cambios emocionales.

Así es Facebook en la Argentina
La red social tiene en el país 23 millones de usuarios, que hacen 1100 millones de comentarios al mes; te mostramos cómo son las oficinas que inauguró Cristina Kirchner esta semana